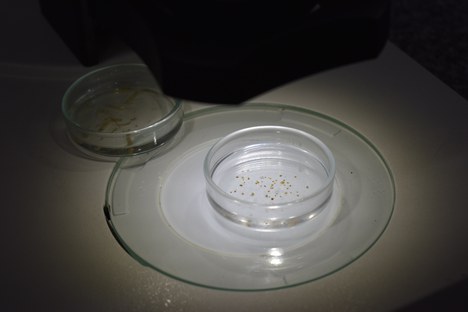
Ação1

Ação 1 - Metagenômica
A Ação 1 consiste na Avaliação da biodiversidade de ictioplâncton do Médio e Baixo Rio Pardo, Bacia do Alto Paraná, por meio de técnicas genéticas e genômicas. Esta ação é coordenada pelo Dr. Fábio Porto Forestii, vinculado à UNESP - campus Bauru.
A amostragem ocorre em cinco pontos do Rio Pardo, situados à jusante e à montante da usina hidrelétrica de Itaipava (Serrana/SP), local onde ocorreu o acidente ambiental de derramamento de vinhaça no Rio Pardo, em 2003.
A triagem em laboratório busca identificar ovos e larvas ao nível taxonômico mais específico possível, comparando índices de ocorrência ao longo dos meses de outubro a janeiro, período de cheia do rio.
Os dados obtidos ao longo dos cinco anos de projeto devem permitir a identificação dos principais grupos de peixes que ocorrem no Rio Pardo, bem como indicar épocas mais suscetíveis de desova e desenvolvimento larval.
Para saber mais: Laboratório de Genética de Peixes (Unesp).